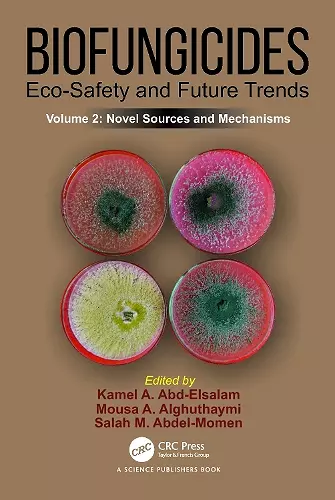
Biofungicides: Eco-Safety and Future Trends cover

Biofungicides: Eco-Safety and Future Trends
Novel Sources and Mechanisms, Volume 2
Kamel A Abd-Elsalam editor Mousa A Alghuthaymi editor Salah M Abdel-Momen editor
Format:Paperback
Publisher:Taylor & Francis Ltd
Published:5th May '25
Currently unavailable, and unfortunately no date known when it will be back
This paperback is available in another edition too:
- Hardback£145.00(9781032590134)
The current volume focuses on novel sources of biofungicides, primarily providing complete knowledge of microbial and phytochemical fungicides, studying antifungal activity mechanisms as well as their role in disease management in plants, and fungicide bioremediation. The use of biofungicides as eco-friendly alternative to typical synthetic fungicides is projected to play a significant role in organic farming in the future.
Key Features:
- Discovers novel sources of biofungicides
- Describes the role of biofungicides in the control of plant diseases
- Studies antifungal activity mechanisms
- Explores how to survey and select promising biofungicides <
ISBN: 9781032590158
Dimensions: unknown
Weight: 560g
326 pages